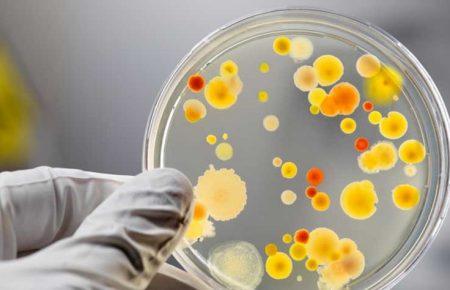
На Тернопільщині в садочку спалах сальмонелозу: зафіксовано 27 хворих

#Лікарі
За тиждень в Україні на кір захворіли 1345 людей, - МОЗ
МОЗ закликає лікарів не брати участь у політичних заходах
МОЗ розробляє документ, який дозволить використовувати вакцину проти кору для дорослих
В Україні за два тижні на кір захворіли 2900 людей, - МОЗ
В Одесі канадські хірурги безкоштовно роблять пластичні операції українським бійцям (ФОТО)
5,5 мільйонів українців уже підписали декларації з лікарями. Це 200-300 тисяч щодня, - Котляревська
Отруєння школярів у Миколаєві: усіх дітей виписують з лікарні
Люди в «сірій зоні» вже звикли звертатися до психологів, - «Лікарі світу»
У територіальних громадах Одещини бракує сімейних лікарів
Російська влада хоче провести медобстеження Сенцова
«Я полгода скрывала от сына, что поехала на фронт», - врач, мама участника боевых действий
Отруєння дітей у Черкасах: розпилена речовина, ймовірно, була не бойовою, а легкою
Заклади охорони здоров’я, які саботуватимуть медреформу, з 2019 року залишаться без фінансування з держбюджету, — Ковтонюк
Щодня понад 100 тисяч українців підписують декларації з лікарями, - МОЗ
В Україні роблять унікальні операції, які дають можливість зберегти серце без трансплантації
В Одеській області у жінки-педіатра виявили туберкульоз
Ректор Чернівецького університету заперечує, що студентів змушують обрати «свого» лікаря (ФОТО)
Кампанія з обрання свого лікаря: розвінчуємо міфи
Розенко закликає звільняти чиновників та лікарів, які саботують медреформу
На Тернопільщині в садочку спалах сальмонелозу: зафіксовано 27 хворих